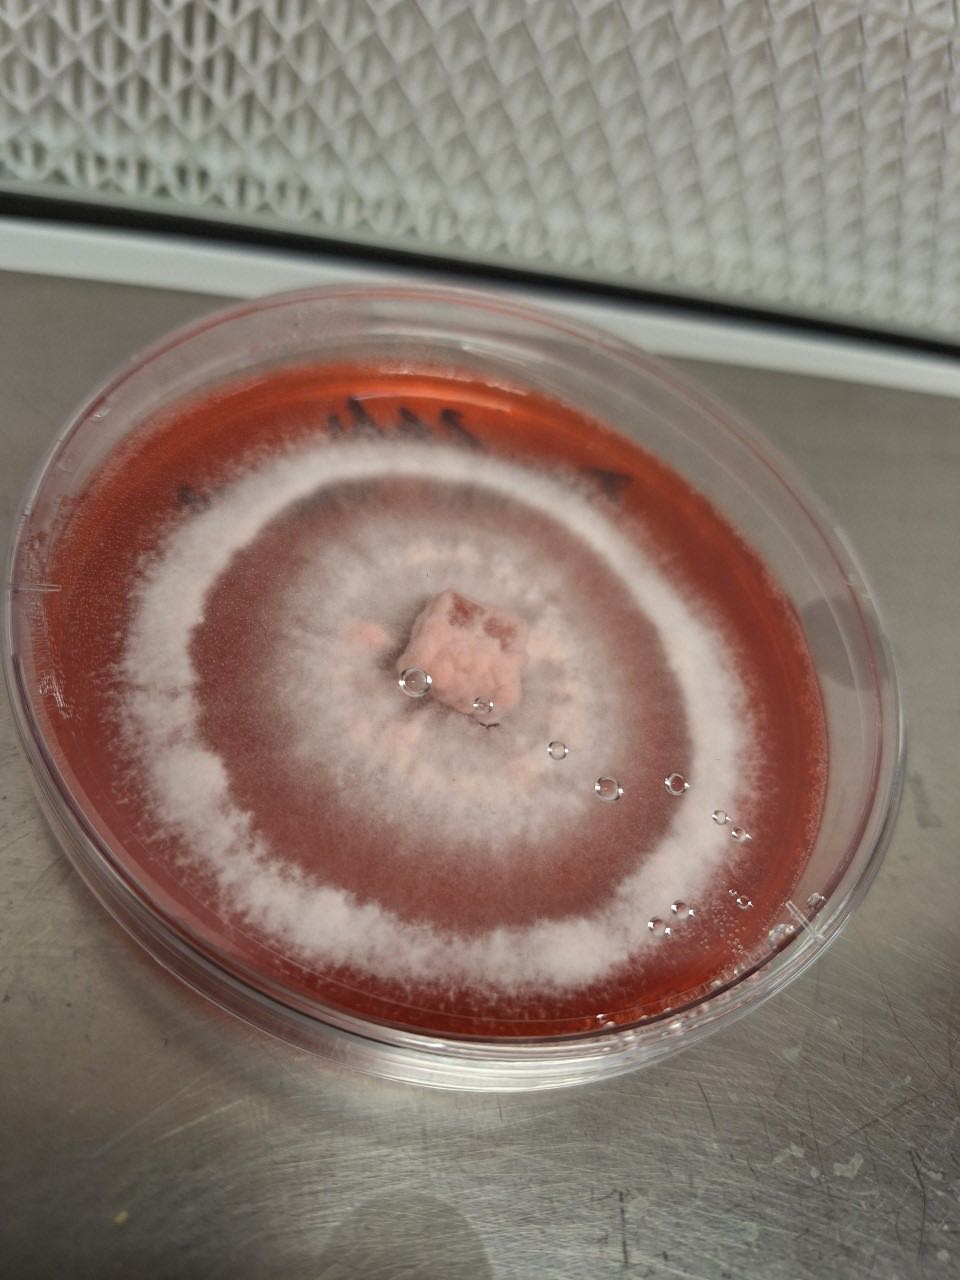
Colonised Agar

Collections
-

Colonised Agar
🍄💉 Buy 3 for 2 on all Colonised Agar 💉🍄 N.B. All...
-

Colonised Grain Spawn
N.B. All products containing mycelium should be used on the day you...
-

Commercial Fruiting Blocks
N.B. All products containing mycelium should be used on the day you...
-

Commercial Liquid Cultures
Grow some beautiful gourmet and medicinal mushrooms. 🍄💉 Buy 5 for 4...
-

Evolved Extracts
🌿 About Evolved Nutritions At Evolved Nutritions, we believe that modern wellness...
-
Fresh Mushrooms
Fresh Mushrooms
-

Mushroom Growing Kits
Fancy growing mushrooms like the pros but without any faff!? Our ready-to-fruit...
-

Mushroom Plug Spawn
Colonised Mushroom Dowels for Log Inoculation Turn logs into living mushroom gardens...
-

Mushroom Products
Check out our range of fresh and dried mushrooms, mushroom coffee and...
-

Native Liquid Cultures
Native Cultures, hand crafted by Jurassic Coast Mushrooms via clones of wild...
-

Test Lab Cultures
Looking for something a little different to grow? This is where you'll...